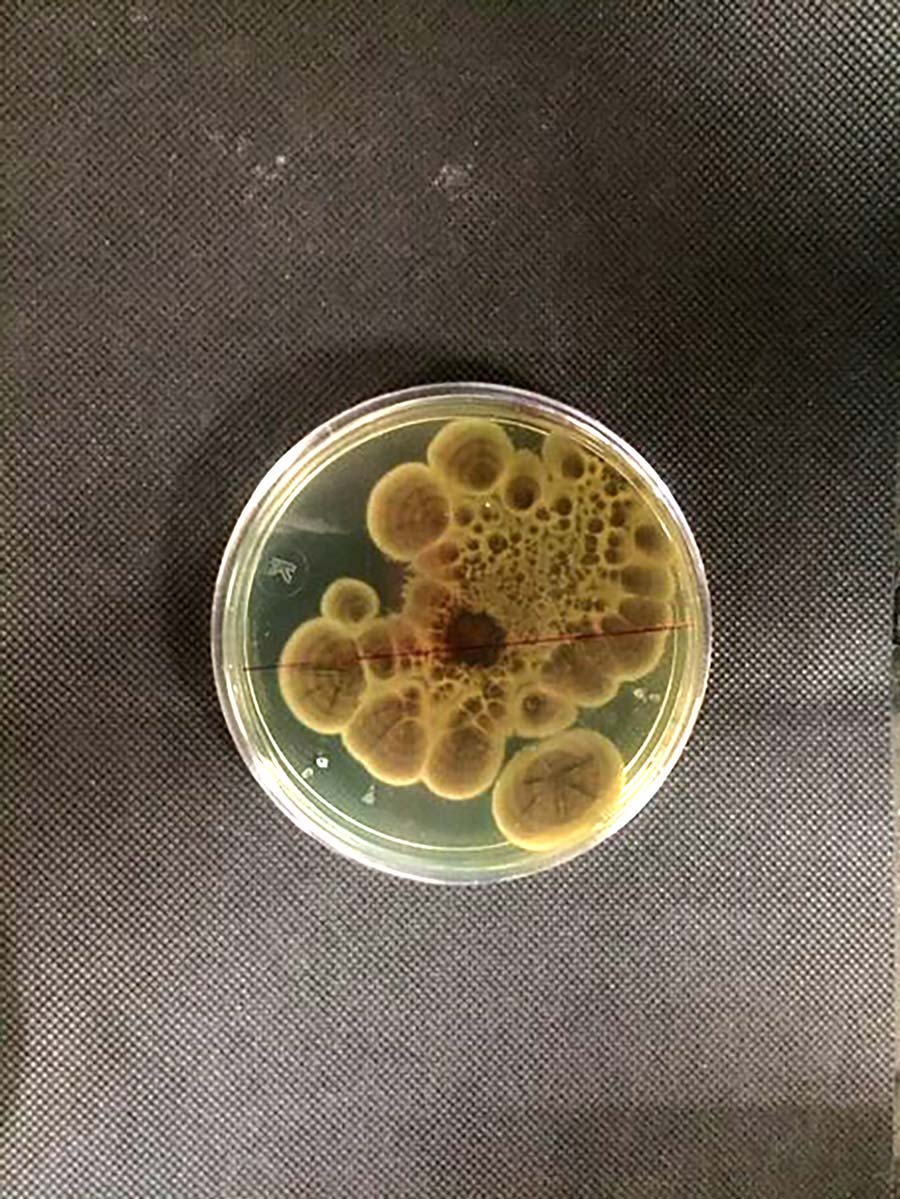
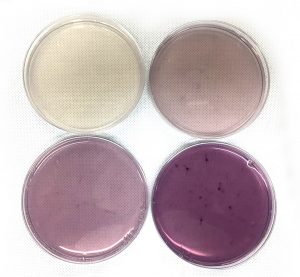
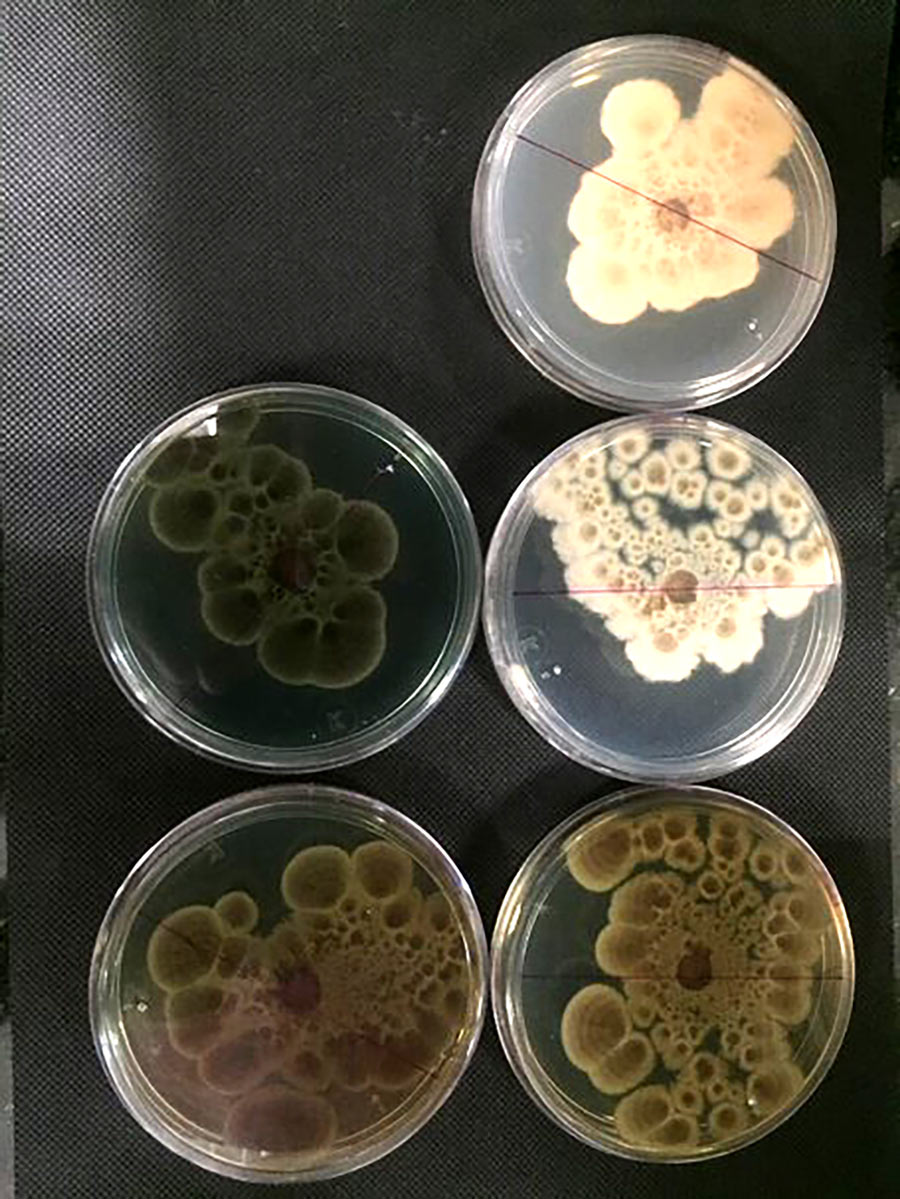
align=aligncenter

受污染淡水中微生物群落生物降解功能
污染是一种选择性压力,它丰富受污染淡水点的微生物某些微生物类可适应流水污染水平,显示代谢能力,允许它们降解污染物Ayixon Sánchez-Reyes博士和Luz Bretón-Deval博士来自墨西哥国立自治大学生物技术学院,研究墨西哥莫雷洛斯Apatlaco本地河流流域的微生物多样性景观团队旨在识别可能对科学大有裨益的新微生物
历史上最受基因组学研究监督的生态系环境源由人类工业活动生成的二维生物物质选择营养塑造了局部微生物景观,改变地球各种环境这一点在严重污染淡水微生物中尤其重要,因为某些微生物类可适应流水污染水平,获取竞争优势并影响微生物多样性
受污染淡水微生物
Ayixon Sánchez-Reyes博士、Luz Bretón-Deval博士及其团队从墨西哥国立自治大学生物技术学院展开雄心勃勃项目,目的是评估墨西哥莫雷洛斯Apatlaco本地河川流域的微生物多样性景观长期目标是重建微生物多样性,从墨西哥自然水流中产生人类污染微生物,并阐明微生物如何应对墨西哥流域纺织业产生的人工污染团队寻找进化适应被织物废物污染环境的微生物适应取决于关键酶演化,使其中一些微生物启动生物降解过程,对科学有用。
染色体近距离绑定
环境科学中最具挑战性的任务之一是将微生物中发生的生态函数与后方特定微生物相连接,特别是当未知物种可能要对特定函数负责时。微生物基因组信息是研究微生物风景源的关键为了识别新物种,科学家分析全环境脱氧核糖核酸,后者隔离分治并随后通过下一代排序技术放大新微生物从祖先分类景观进化的精度点由高受保护标记识别,如核子脱氧核糖核酸或单片蛋白编码序列上表方法尽管测序有进步,但对混合群仍有一些限制,例如极有可能集合非代表性基因组序列研究者使用替代方法汇编更完整和可靠的基因组信息方法称相位离合法分解法(见Burtonetal等)使用遗传序列物理邻接信号合用单元相关序列随后起遗传签名作用,以重构高质量基因组并与特定代谢函数相关
sánchez-Reyes和Bretón-deval向淡水和沉积微生物样本提供蓝炭字织染色团队从Apatlaco河流域采集淡水样本(Morelos,Mex共确定并评价97个元组分基因组的染分分解基因组项目首创, 首次分析织物生物群落, 并首创解构Apatlaco河微生物群落泥沙研究, 受Morelos州人类活动影响最大的流域

织物染色的长期影响
Apatlaco河流流域为探索人类生成的污染对微生物多样性的影响提供完美条件,并以此作为研究模型团队分析表层水和沉积样本,并有炭膜染色深蓝35(TM)为唯一碳源历时一个月的孵化过程后,样本通过商业版基因组包筛选,使研究人员能够识别与织物环境相关联的新奇物种。遗传分类显示Methanobacterium沼气配方原型归归宿域 表示大约50%的织物染色体22%和11%的人口概况表示克隆人并Cupriavidus互斥其余分布与新奇物种对应,没有清晰分类立体
了解微生物多样性是处理环境污染、生物多样性丧失和公共卫生等全球性问题的重要组成部分。
深蓝35解析率分析30天孵化显示染色结构极耐退化团队方法旨在模拟向淡水环境排出纺织品时会发生什么数据汇总显示,在本地微生物对污染物进行重大修改前,纺织品染料对淡水的影响可产生长期持久效果。团队假设织交降解活动与多益倍增酶相关联,这些酶使用过氧化氢作为电导体并可能为二维生物激活蛋白质以及多酚氧化酶由于这些酶可与纺织品染色物降解型态相关联,它们可充当纺织品废水处理厂环境监测标志
Dye降解能力
上文描述的探索性研究发现一个新菌株,由Sánchez-Reyes和Bretón-Deval分类为'卡迪达图斯Afiaaplaquensis发现启发团队在2020年发布首份报告阿斐比亚基因资源集成于织物-dye生物修复环境的丰富河流沉积生物群阿斐比亚物种被广泛称为人和动物病原体,通常与人源或医院水供应隔离基因组分析建议似然分子函数
团队旨在绘制墨西哥淡水栖息地新本地微生物地图并识别新微生物环境作用以上所述工作的潜在应用并不限于识别有能力降解织物染料的微生物更好地了解微生物适应地球生命的各种进化策略可能导致发现对科学有用的微生物举例说,微生物中甲烷代谢植物型的流行在碳循环中可能很重要此外,对有营养选择社区的研究使人们有可能解释具体遗传系如何与各种代谢过程相关联,从塑料退化能力到某些细菌显示抗生素抗药性不等。

个人响应
下一步研究是什么特别是在生物降解应用方面,这些应用可能有益于环境科学
下一步首先包括验证这项工作产生的假设,特别是关于可能降解性活动织染的酶假设我们打算实战条件评估实验室内这些酶的活动第二,我们打算隔离描述亚普拉科河新物种背景,帮助绘制本地微生物多样性地图并加深理解二维生物分解

